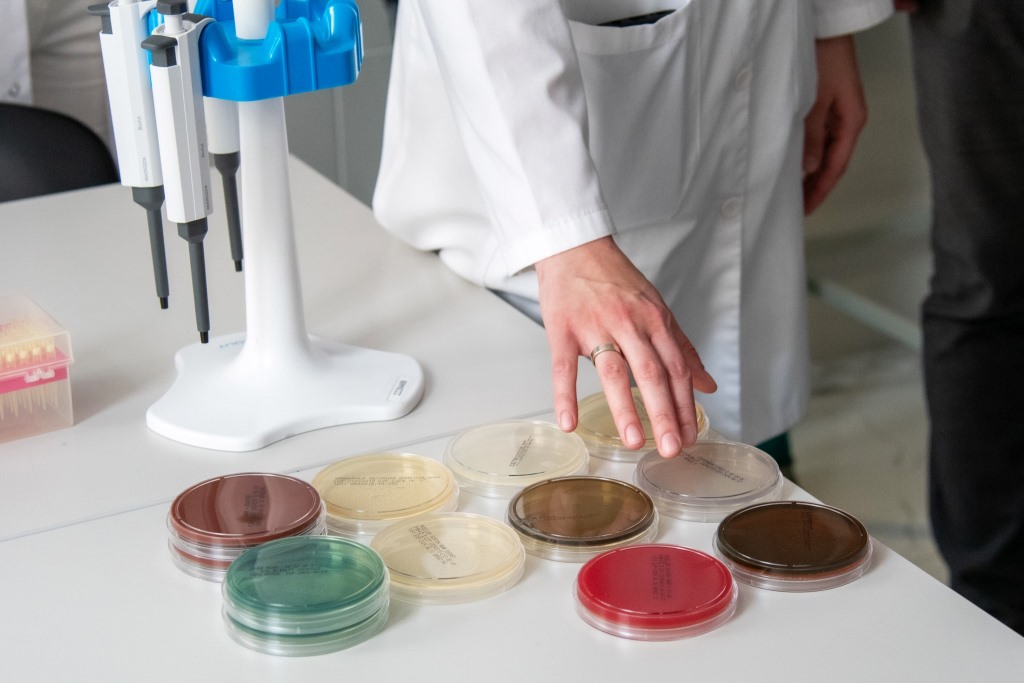

20:19, 28 Травня 2024
У Волинській обласній лікарні відкрили сучасну баклабораторію
Новостворений підрозділ оглянули сьогодні голова обласної ради Григорій Недопад, його заступник Григорій Пустовіт, заступник очільника наглядової ради медустанови, депутат Ігор Лех, начальник ОВА Юрій Погуляйко та керівник обласного управління охорони здоров’я Юрій Легкодух.
Про це повідомляють на сторінці Волинської облради у «Фейсбук».
Відділення інфекційного контролю вирішуватиме одночасно кілька важливих завдань: попередження інфекційних хвороб та лікарняних інфекцій, визначення чутливості до різного типу антибіотиків, рівня стерильності біологічних рідин, що своєю чергою суттєво підвищить ефективність антимікробної терапії та знизить ризики антибіотикорезистентності.
«Досі цю послугу ми закуповували в іншого медичного закладу. Проте у лікарні нашого рівня за вимогами НСЗУ має бути власна баклабораторія. І якщо раніше для отримання результату потребувався тиждень, то тепер ідентифікувати збудники та визначати його чутливість можна буде за добу-дві, що сприятиме швидкому призначенні антибіотикотерапії. Крім того відкриття бактеріологічної лабораторії дозволить повністю відповідати статусу «Чиста лікарня – безпечна для пацієнта», – розповів керівник обласної клінічної лікарні Олександр Дудар.
На 300 квадратних метрах нового відділення втілено усі стандарти безпеки і контролю, встановлено новітнє лабораторне обладнання, навчено персонал. На реконструкцію та обладнання знадобилося понад пів року і майже 9 мільйонів гривень. 4,4 мільйона забезпечив обласний бюджет на закупівлю устаткування, 2,4 мільйона – кошти лікарні, які спрямували на придбання медичних меблів та інструментарію, ще два мільйони гривень – це партнерська підтримка компанії «Ормед» на ремонтні роботи.
«Я щиро дякую усім за спільний внесок у цю дуже важливу справу. Її результат – це якісна послуга, безпечне лікарняне середовище, а ще економічна доцільність, оскільки вдасться суттєво скоротити час, інтенсифікувати ліжкообіг і пролікувати більшу кількість пацієнтів», – запевнив Олександр Дудар.
Він також поділився планами через систему тендерних закупівель пропонувати послугу з бактеріологічних досліджень іншим медичним установам області.
«За оснащенням ця лабораторія напевно найсучасніша на західних теренах. І я щиро вітаю персонал лікарні з черговим, але не останнім успішно реалізованим інноваційним проектом. Це ще один крок до надання якісної і безпечної меддопомоги. Не слід легковажити й економічним ефектом у цей скрутний час: кошти, вкладені у це відділення, цілком можуть окупитися упродовж трьох років й надалі приносити лікарні додаткові асигнування», – підсумував голова Волиньради Григорій Недопад.

Залишити відповідь